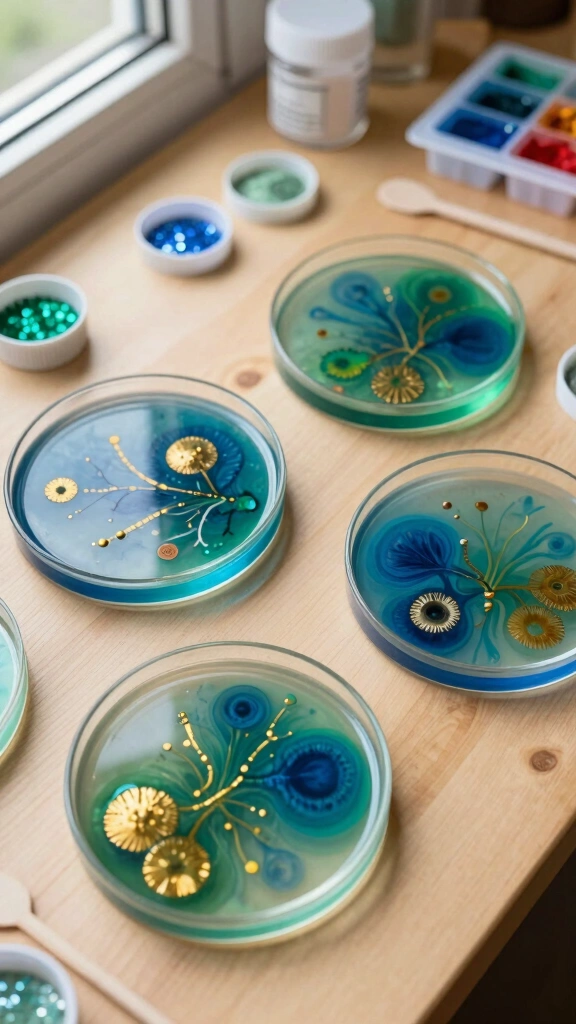
Petri Dish Art

Ever thought about diving into the mesmerizing world of resin crafts? If you’re like me, you probably crave that sweet mix of creativity and a little bit of chemistry. ☺️ From dazzling coasters to stunning jewelry, resin allows you to unleash your inner artist. Plus, who doesn’t love a good DIY project that doubles as home decor? Whether you’re a newbie or a seasoned craft pro, I’ve got you covered with 17 fantastic resin craft tutorials that’ll spark your imagination. Let’s get crafting!
1. Vibrant Resin Coasters

Coasters are a staple in any home, but why not make them pop with color? This vibrant resin coaster tutorial shows you how to create stunning, one-of-a-kind pieces. With just a few colors and some glitter, you can transform your boring coffee table into a statement piece. Imagine impressing your guests with coasters that look like a piece of art!
2. Resin Jewelry with Dried Flowers

Did someone say boho vibes? 🌼 This resin jewelry tutorial combines nature and style in the most beautiful way. Using dried flowers embedded in resin, you can craft beautiful earrings, necklaces, and rings. It’s the perfect project for a rainy day and a fantastic way to cherish those little blooms you love.
3. Colorful Resin Wall Art

If walls could talk, I bet they’d scream for some resin art! 😍 This colorful resin wall art tutorial makes it easy to create stunning pieces that can brighten up any room. Just mix your favorite colors and pour them onto a canvass. Easy-peasy, and you’ll feel like a Picasso in no time!
4. DIY Resin Keychains

Keychains are not just practical; they can also be mini masterpieces! In this DIY resin keychain tutorial, you’ll learn how to create adorable and personalized keychains using mold shapes and fun inclusions like glitter or beads. Trust me, your keys will thank you for the upgrade!
5. Petri Dish Art
Unleash your inner scientist! This petri dish resin art tutorial captures the beauty of science in your home decor. Create mesmerizing designs that mimic real dish cultures. It’s a fun project that gives your home a quirky touch, and who wouldn’t want to have a science-themed piece hanging around?
6. Resin Phone Stand

We all have those moments when we need a phone stand—especially while watching videos. This resin phone stand tutorial will teach you how to craft a sleek and functional stand that fits perfectly in your style. Plus, every time you use it, you can feel proud of your handiwork!
7. Stunning Resin River Table

Everyone swoons over beautiful furniture, and what could be more awe-inspiring than a resin river table? This resin river table tutorial walks you through creating a stunning coffee table that breaks the mold of ordinary furniture. It’s a bit more advanced, but the results will have your home looking like a fancy showroom!
8. Resin Picture Frames

Want to elevate your photo game? This resin picture frame tutorial takes your favorite memories and adds some flair to them. Customize your frames with color, glitter, and even small trinkets. They make for great personalized gifts too—after all, who doesn’t love a unique frame?
9. Glitter Resin Pens

Writing never looked so good! Create these glitter resin pens to transform your stationery. They’re practical, stylish, and make every note-taking session feel fancy. Give them out as gifts or keep them for yourself—no judgment here! 🖊️
10. Faux Agate Resin Slice Coasters

These faux agate coasters are oh-so-stylish and not as complicated as they look. By using resin and some coloring techniques, you can replicate that gorgeous stone look. They’ll add an elegant touch to your dining room while showing off your crafting skills!
11. Droid-Inspired Resin Clips

For the tech lovers out there, this droid-inspired resin clips tutorial combines functionality and creativity. Create adorable clips that can hold your notes or pictures. It’s a playful way to stay organized, and let’s face it, they’ll make your workspace so much cooler!
12. Decorative Resin Bookmarks

Reading just got an upgrade! These decorative resin bookmarks will keep your place in style. Add colorful inclusions or personalize them with names to make perfect gifts for your bookworm friends. They’ll thank you every time they pick up their latest read!
13. Resin Candle Holders

Nothing sets the mood quite like a flickering candle. Try making resin candle holders in vibrant colors. They look gorgeous and can be customized for any season or occasion. Plus, your guests will wonder where you found such beautiful pieces!
14. Resin Charcuterie Boards

If you love entertaining or just enjoy snacking, this resin charcuterie board tutorial is a must-try! Combine wood and resin for a stunning serving piece that’ll have everyone talking. Plus, it’s super simple to make and looks so professional!
15. Mixed Media Resin Wall Hangings

Channel your creativity with mixed media resin wall hangings. This craft combines various textures and colors to create beautiful art pieces for your wall. The possibilities are endless, and each one turns out unique—just like you!
16. Resin Flowers Wall Art

Create a lasting impression with resin flowers wall art that captures the beauty of nature. You’ll embed real or faux flowers in resin, bringing the great outdoors indoors. It’s a sweet reminder of springtime whenever you look at it!
17. Resin Planter Pots
Give your plants a stylish new home with these resin planter pots. You can customize the colors and designs to fit your decor. They’ll add personality to your indoor jungle while showcasing your crafting prowess. After all, even your plants deserve to live in style!
There you have it—17 fabulous resin crafts tutorials that’ll keep your creative juices flowing! Whether you’re a budding artist or simply looking to try something new, these projects offer something for everyone. Crafting in resin isn’t just a hobby; it’s a way to express yourself and create unique pieces that can elevate your space. Now, which project are you diving into first? Let’s get to work! 😄
